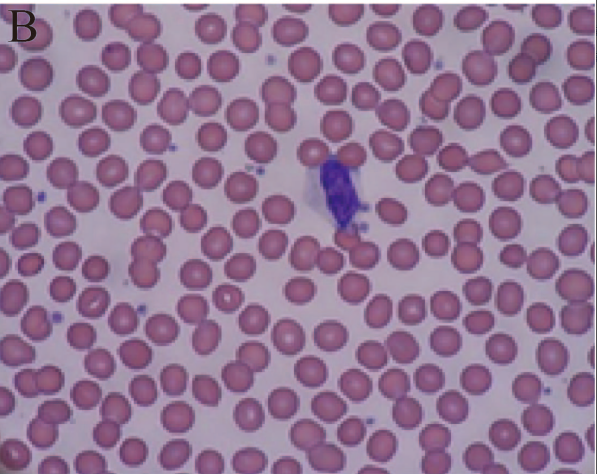

题库
-
.单选题
-
"> 正确答案:|以下哪种细胞密度适合免疫荧光染色?
">

答题解析:无 -
选出 MSCs细胞形态:

答题解析:无
每大格的细胞数最好在什么范围内比较准确?
正确答案:
50~100个
答题解析:无
如下图所示,该细胞悬液每ml大约有( )个细胞。
2×106
5×106
5×105
2×105
5×105
5×105
答题解析:无
细胞计数板中每大格的体积为( )
正确答案:
0.1 mm3
答题解析:无